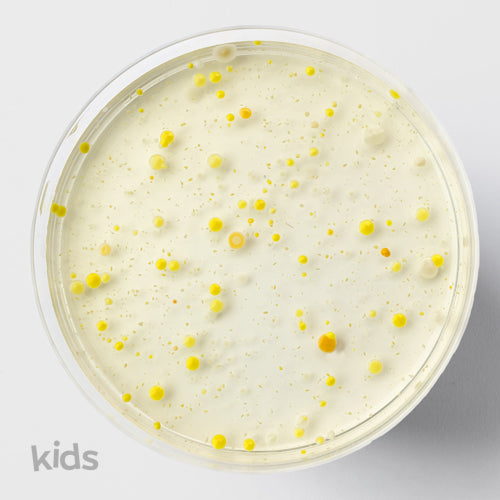
LactoSpore® Probiotic

1
/
of
1
Nourished US
LactoSpore® Probiotic
LactoSpore® Probiotic
Regular price
$0.00 USD
Regular price
Sale price
$0.00 USD
Taxes included.
Quantity
Couldn't load pickup availability
Share